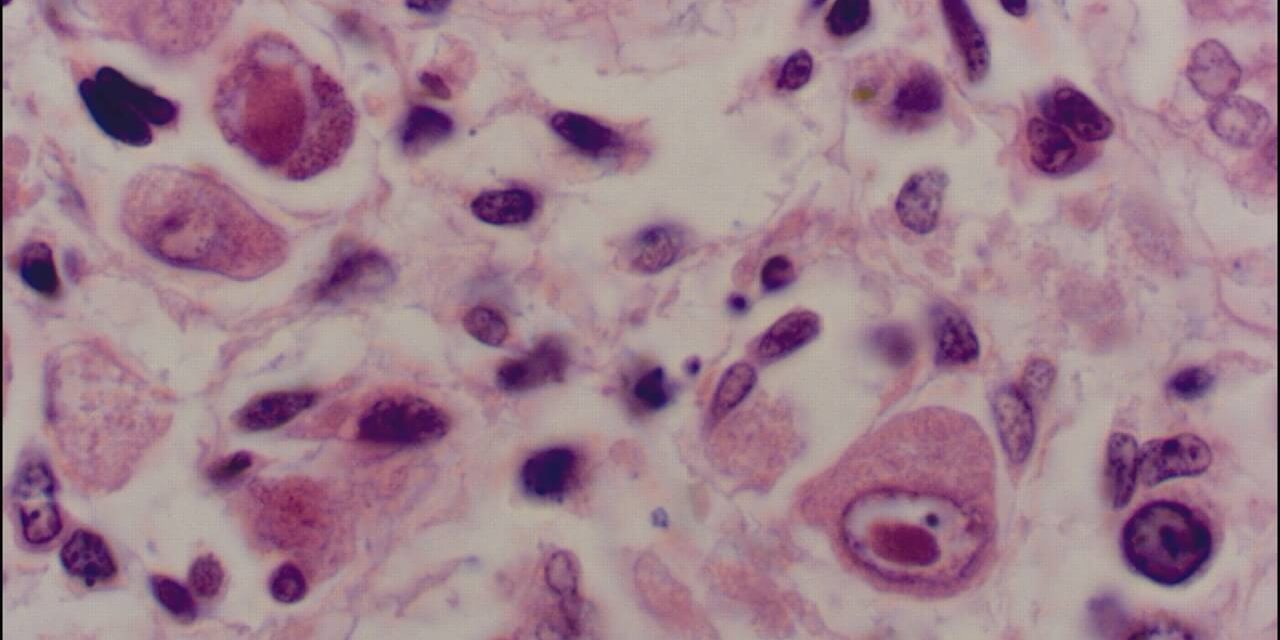

Инфекциите се најчести причини за предвремено породување. Инфекциите во бременоста може да бидат бактериски, габични, вирусни, предизвикани од паразити.
Во случај на ненавремено препознавање и лекување на инфекциите, тие сериозно може да ја загрозат бременоста и да доведат до спонтан абортус, предвремено породување, како и до раѓање на бебе со ниска родилна тежина.
За да се избегнат сите компликации врзани за бременост потребно е плански, односно пред бременоста, да се направи микробиолошка анализа. Ако некои од причинителите на инфекцијата се докажат, тогаш е потребна терапија. На тој начин може да се избегнат бројни компликации кои го спречуваат остварувањето на здрава бременост.
Превенцијата со микробиолошките скрининзи во 12, 24 и 35 гестациска недела од бременоста овозможува откривање и инфекции кои се без симптоми, со што значително се намалува процентот на ризиците и компликациите кои може да настанат како нивна последица.